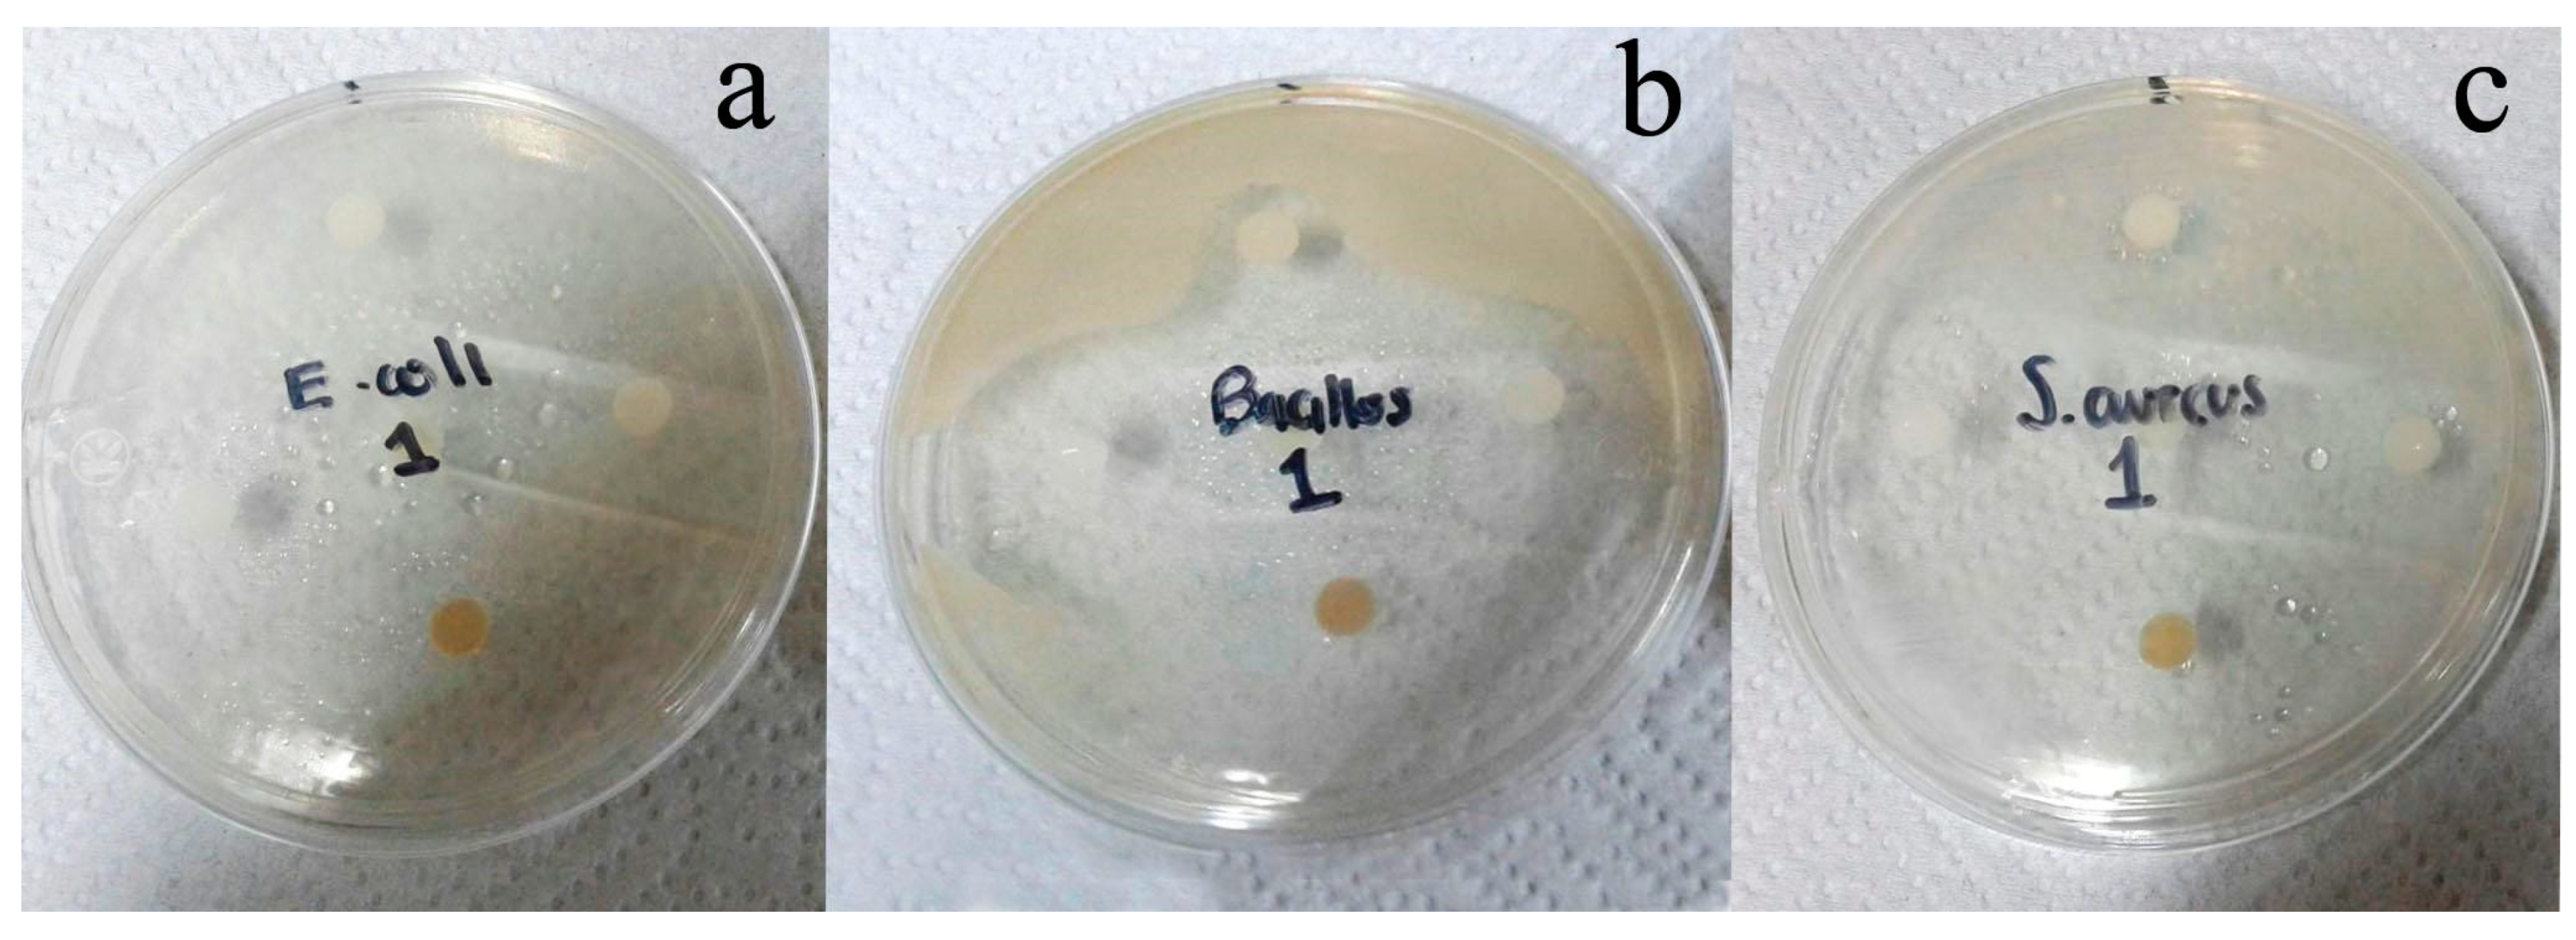
Medicines 07 00059 g001

Composition and Antibacterial Activity of the Essential Oil from Pimenta dioica (L.) Merr. from Guatemala
Abstract
1. Introduction
2. Materials and Methods
2.1. Plant Material
2.2. Extraction of Essential Oil
2.3. Gas Chromatography Coupled to Mass Spectrometry Analysis (GC/MS)
2.4. Antibacterial Activity
3. Results
3.1. Chemical Composition of the Essential Oil of P. dioica
3.2. Antibacterial Activity
4. Discussions
Supplementary Materials
Author Contributions
Funding
Conflicts of Interest
References
- McVaugh, R. Flora of Guatemala. Fieldiana Bot. 1963, 24, 382–385. [Google Scholar]
- Raghavan, S. Handbook of Spices, Seasonings, and Flavorings, 2nd ed.; CRC Press: Boca Raton, FL, USA, 2006; pp. 64–66. [Google Scholar]
- NIIR Board of Consultants & Engineers. The Complete Book on Spices & Condiments (with Cultivation, Processing & Uses), 2nd ed.; Asia Pacific Business Press Inc.: New Delhi, India, 2008; pp. 37–38. [Google Scholar]
- Nakatani, N. Antioxidative and Antimicrobial Constituents of Herbs and Spices. In Spices, Herbs and Edible Fungi, 1st ed.; Charalambous, G., Ed.; Elsevier: Amsterdam, The Netherlands, 1994; pp. 251–271. [Google Scholar]
- Volpato, G.; Godínez, D.; Beyra, A.; Barreto, A. Uses of medicinal plants by Haitian immigrants and their descendants in the Province of Camagüey, Cuba. J. Ethnobiol. Ethnomed. 2012, 13, 1900–1906. [Google Scholar] [CrossRef] [PubMed]
- Nayak, Y.; Abhilash, D.; Vijaynarayana, K.; Fernandes, J. Antioxidant and hepatoprotective activity of Pimenta dioica leaves extract. J. Cell Tissue Res. 2008, 8, 1571–1576. [Google Scholar]
- Padmakumari, K.P.; Sasidharan, I.; Sreekumar, M.M. Composition and antioxidant activity of essential oil of pimento (Pimenta dioica (L) Merr.) from Jamaica. Nat. Prod. Res. 2011, 25, 152–160. [Google Scholar] [CrossRef] [PubMed]
- Lorenzo-Leal, A.C.; Palou, E.; López-Malo, A.; Bach, H. Antimicrobial, cytotoxic, and anti-inflammatory activities of Pimenta dioica and Rosmarinus officinalis essential oils. BioMed Res. Int. 2019. [Google Scholar] [CrossRef] [PubMed]
- Sabino, F.P.; Reyes, M.M.; Taracena, E.; Oliva, B.; Wug, M.M.; Martínez, J.V.; Simas, D.L.R.; Silva, A.J.R. Chemical composition of the essential oil of Pimenta dioica (L.) Merrill from Guatemala. Rev. Virtual Quim. 2015, 8, 75. [Google Scholar]
- Dharmadasa, R.M.; Abeysinghe, D.C.; Dissanayake, D.M.N.; Abeywardhane, K.W.; Fernando, N.S. Leaf essential oil composition, antioxidante activity, total phenolic content and total flavonoid content of Pimenta dioica (L.) Merr (Myrtaceae): A superior quality spice grown in Sri Lanka. Univ. J. Agric. Res. 2015, 3, 49–52. [Google Scholar]
- Marongiu, B.; Piras, A.; Porcedda, S.; Casu, R.; Pierucci, P. Comparative analysis of supercritical CO2 extract and oil of Pimenta dioica leaves. J. Essent. Oil Res. 2005, 17, 530–532. [Google Scholar] [CrossRef]
- Marzouk, M.S.A.; Moharram, F.A.; Mohamed, M.A.; Gamal-Eldeen, A.M.; Aboutabl, E.A. Anticancer and antioxidant tannins from Pimenta dioica leaves. Z. Nat. A 2007, 62, 526–536. [Google Scholar] [CrossRef]
- Al-Rehaily, A.J.; Al-Said, M.S.; Al-Yahya, M.A.; Mossa, J.S.; Rafatullah, S. Ethnopharmacological studies on allspice (Pimenta dioica) in laboratory animals. Pharm. Biol. 2002, 40, 200–205. [Google Scholar] [CrossRef]
- Suárez, A.; Ulate, G.; Ciccio, J. Hypotensive action of an aqueous extract of Pimenta dioica (Myrtaceae) in rats. Rev. Biol. Trop. 2000, 48, 53–58. [Google Scholar] [PubMed]
- Park, I.-K.; Kim, J.; Lee, S.-G.; Shin, S.-C. Nematicidal activity of plant essential oils and components from Ajowan (Trachyspermum ammi), Allspice (Pimenta dioica) and Litsea (Litsea cubeba) essential oils against pine Wood Nematode (Bursaphelenchus xylophilus). J. Nematol. 2007, 39, 275–279. [Google Scholar] [PubMed]
- Martinez-Velazquez, M.; Castillo-Herrera, G.A.; Rosario-Cruz, R.; Flores-Fernandez, J.M.; Lopez-Ramirez, J.; Hernandez-Gutierrez, R.; Lugo-Cervantes, E.d.C. Acaricidal effect and chemical composition of essential oils extracted from Cuminum cyminum, Pimenta dioica and Ocimum basilicum against the cattle tick Rhipicephalus (Boophilus) microplus (Acari: Ixodidae). Parasitol Res. 2011, 108, 481–487. [Google Scholar] [CrossRef] [PubMed]
- Asha, M.M.; Chaithra, M.; Yashoda, K.; Vivek, M.N.; Prashith Kekuda, T.R. Antibacterial activity of leaf and bark extracts of Pimenta dioica (Linn.) Merill against clinical isolates of Staphylococcus aureus and Streptococcus mutans. World J. Pharm. Pharm. Sci. 2013, 2, 3207–3215. [Google Scholar]
- Khandelwal, P.; Upendra, R.S.; Raftaniamiri, Z.; Ramachandra, G.G. Assessment of biotherapeutic potential of Pimenta dioica (allspice) leaf extract. Int. J. Pharm. Sci. Res. 2012, 3, 3379–3383. [Google Scholar]
- Lowe, H.I.C.; Daley, D.K.; Lindo, J.; Davis, C.; Rainford, L.; Hartley, S.-A.; Watson, C.; Chambers, C.; Reynolds-Campbell, G.; Foster, S.R.; et al. The antibacterial and antifungal analysis of crude extracts from leaves and bark of Pimenta species found in Jamaica. J. Med. Plant Res. 2017, 11, 591–595. [Google Scholar]
- Boyd, F.A.H.; Benkeblia, N. In vitro evaluation of antimicrobial activity of crude extracts of Pimenta dioica L. (Merr.). Acta Hortic. 2014, 1047, 199–205. [Google Scholar] [CrossRef]
- Kumar, B.H.; Badarudin, A.; Jose, A. DPPH radical scavenging activity and antibacterial activity of Pimenta dioica (L.) Merr. Orient. J. Chem. 2010, 26, 1501–1505. [Google Scholar]
- Kamble, V.A. In vitro anticandidal activity of Pimenta dioica (allspice) essential oil against clinical isolates of Candida albicans and non-albicans Candida. Int. J. Life Sci. Pharma Res. 2012, 2, 150–158. [Google Scholar]
- Adams, R.P. Identification of Essential Oil Components by Gas Chromatography/Mass Spectrometry, 4.1 ed.; Allured Publishing: Carol Stream, IL, USA, 2017; p. 374. [Google Scholar]
- Cavalieri, J.S.; Harbeck, R.J.; McCarter, Y.S.; Ortez, J.H.; Rankin, I.D.; Sautter, R.L.; Sharp, S.E.; Spiegel, C.A. Manual de Pruebas de Suceptibilidad Antimicrobina; American Society for Microbiology: Washington, DC, USA, 2005. [Google Scholar]
- Laboratorio de Bioensayos. Procedimientos Estándar de Operación; Universidad de San Carlos de Guatemala: Guatemala City, Guatemala, 2000. [Google Scholar]
- López-Ávila, K.; Dzul-Rosado, K.; Lugo-Caballero, C.; Arias-León, J.; Zavala-Castro, J. Mecanismos de resistencia antifúngica de los azoles en Candida albicans. Rev. Biomed. 2016, 27, 127–136. [Google Scholar] [CrossRef][Green Version]
- Mitscher, L.A.; Leu, R.P.; Bathala, M.S.; Wu, W.N.; Beal, J.L. Antimicrobial agents from higher plants. 1. Introduction, rationale and methodology. Lloydia 1972, 35, 157–166. [Google Scholar] [PubMed]
- Murray, P.; Kobayashi, G.; Pfalleer, M.; Rosenthal, K. Microbiología Médica, 8th ed.; Elsevier: Amsterdam, The Netherlands, 2017. [Google Scholar]
- Pavesi, C.; Banks, L.A.; Hudaib, T. Antifungal and antibacterial activities of eugenol and non-polar extract of Syzygium aromaticum L. J. Pharm. Sci. Res. 2018, 10, 337–339. [Google Scholar]
- Mak, K.-K.; Kamal, M.B.; Ayuba, S.B.; Sakirolla, R.; Kang, Y.-B.; Mohandas, K.; Balijepalli, M.K.; Ahmad, S.H.; Pichika, M.R. A comprehensive review on eugenol’s antimicrobial properties and industry applications: A transformation from ethnomedicine to industry. Pharmacogn. Rev. 2019, 13, 1–9. [Google Scholar]
| Compound Id (MS) | SI | KI exp | KI Adams | % (Fruits) | % (Leaves) |
|---|---|---|---|---|---|
| β-myrcene | 96 | 991.9 | 991 | 10.1 | 10.0 |
| α-terpinene | 94 | 1018.0 | 1017 | 0.1 | t |
| o-cymene | 93 | 1025.2 | 1026 | 0.1 | 0.1 |
| limonene | 95 | 1029.6 | 1029 | 0.4 | 0.4 |
| 1,8-cineole | 97 | 1032.8 | 1031 | 0.8 | 1.6 |
| (E)-β-ocimene | 96 | 1045.7 | 1050 | 1.3 | 1.8 |
| γ-terpinene | 95 | 1057.9 | 1060 | 0.2 | t |
| terpinolene | 95 | 1085.9 | 1089 | 0.3 | 0.2 |
| linalool | 96 | 1101.5 | 1097 | 1.6 | 0.8 |
| Terpinen-4-ol | 96 | 1180.8 | 1177 | 1.0 | 0.6 |
| α-terpineol | 95 | 1195.4 | 1189 | 0.1 | 0.2 |
| chavicol | 96 | 1251.4 | 1250 | 0.8 | 3.1 |
| eugenol | 97 | 1363.7 | 1359 | 65.9 | 71.4 |
| NI | --- | 1368.1 | 1369 | 0.1 | nd |
| α-ylangene | 94 | 1375.6 | 1375 | 1.2 | t |
| NI | --- | 1388.6 | --- | t | 0.2 |
| methyleugenol | 89 | 1401.7 | 1404 | 1.9 | 0.1 |
| (E)-caryophyllene | 95 | 1418.8 | 1419 | 9.1 | 5.2 |
| α-humulene | 95 | 1452.3 | 1455 | 1.2 | 1.1 |
| γ-muurolene | 92 | 1472.1 | 1480 | 0.2 | t |
| germacrene D | 93 | 1477.4 | 1485 | 0.4 | t |
| NI | --- | 1487.1 | -- | 0.1 | 0.5 |
| NI | --- | 1491.6 | --- | 0.2 | 0.6 |
| NI | --- | 1509.3 | --- | 0.1 | t |
| δ-amorphene | 90 | 1515.3 | 1512 | 0.8 | t |
| caryophyllene oxide | 91 | 1576.0 | 1583 | 0.4 | 0.7 |
| NI | --- | 1611.8 | --- | nd | 0.2 |
| NI | --- | 1650.3 | --- | 0.1 | 0.7 |
| NI | --- | 1943.8 | --- | 0.3 | nd |
| NI | --- | 1978.8 | --- | 0.1 | nd |
| 98.9 | 99.5 |
| Strain | Inhibition zone (mm) (Average ± Standard Deviation) |
|---|---|
| Escherichia coli ATCC 8739 | 16 ± 1.0 |
| Bacillus subtilis ATCC 6633 | 23 ± 1.2 |
| Staphylococcus aureus ATCC 25923 | 20 ± 0.6 |
| Salmonella enterica Tiphymurium | 22 ± 0.6 |
© 2020 by the authors. Licensee MDPI, Basel, Switzerland. This article is an open access article distributed under the terms and conditions of the Creative Commons Attribution (CC BY) license (http://creativecommons.org/licenses/by/4.0/).
Share and Cite
Mérida-Reyes, M.S.; Muñoz-Wug, M.A.; Oliva-Hernández, B.E.; Gaitán-Fernández, I.C.; Simas, D.L.R.; Ribeiro da Silva, A.J.; Pérez-Sabino, J.F. Composition and Antibacterial Activity of the Essential Oil from Pimenta dioica (L.) Merr. from Guatemala. Medicines 2020, 7, 59. https://doi.org/10.3390/medicines7100059
Mérida-Reyes MS, Muñoz-Wug MA, Oliva-Hernández BE, Gaitán-Fernández IC, Simas DLR, Ribeiro da Silva AJ, Pérez-Sabino JF. Composition and Antibacterial Activity of the Essential Oil from Pimenta dioica (L.) Merr. from Guatemala. Medicines. 2020; 7(10):59. https://doi.org/10.3390/medicines7100059
Chicago/Turabian StyleMérida-Reyes, Max Samuel, Manuel Alejandro Muñoz-Wug, Bessie Evelyn Oliva-Hernández, Isabel Cristina Gaitán-Fernández, Daniel Luiz Reis Simas, Antonio Jorge Ribeiro da Silva, and Juan Francisco Pérez-Sabino. 2020. "Composition and Antibacterial Activity of the Essential Oil from Pimenta dioica (L.) Merr. from Guatemala" Medicines 7, no. 10: 59. https://doi.org/10.3390/medicines7100059
APA StyleMérida-Reyes, M. S., Muñoz-Wug, M. A., Oliva-Hernández, B. E., Gaitán-Fernández, I. C., Simas, D. L. R., Ribeiro da Silva, A. J., & Pérez-Sabino, J. F. (2020). Composition and Antibacterial Activity of the Essential Oil from Pimenta dioica (L.) Merr. from Guatemala. Medicines, 7(10), 59. https://doi.org/10.3390/medicines7100059

